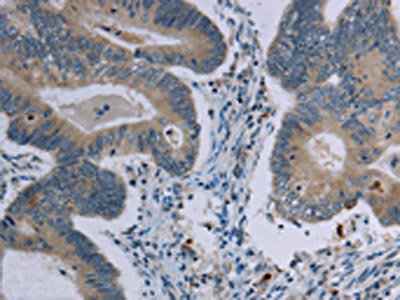

-
中文名稱:MARVELD1兔多克隆抗體
-
貨號:CSB-PA106910
-
規格:¥1100
-
圖片:
-
The image on the left is immunohistochemistry of paraffin-embedded Human cervical cancer tissue using CSB-PA106910(MARVELD1 Antibody) at dilution 1/40, on the right is treated with synthetic peptide. (Original magnification: ×200)
-
The image on the left is immunohistochemistry of paraffin-embedded Human colon cancer tissue using CSB-PA106910(MARVELD1 Antibody) at dilution 1/40, on the right is treated with synthetic peptide. (Original magnification: ×200)
-
Gel: 10%SDS-PAGE, Lysate: 40 μg, Lane: Mouse heart tissue, Primary antibody: CSB-PA106910(MARVELD1 Antibody) at dilution 1/300, Secondary antibody: Goat anti rabbit IgG at 1/8000 dilution, Exposure time: 10 minutes
-
-
其他:
產品詳情
-
Uniprot No.:
-
基因名:MARVELD1
-
別名:MARVELD1; MRVLDC1; MARVEL domain-containing protein 1
-
宿主:Rabbit
-
反應種屬:Human,Mouse
-
免疫原:Synthetic peptide of Human MARVELD1
-
免疫原種屬:Homo sapiens (Human)
-
標記方式:Non-conjugated
-
抗體亞型:IgG
-
純化方式:Antigen affinity purification
-
濃度:It differs from different batches. Please contact us to confirm it.
-
保存緩沖液:-20°C, pH7.4 PBS, 0.05% NaN3, 40% Glycerol
-
產品提供形式:Liquid
-
應用范圍:ELISA,WB,IHC
-
推薦稀釋比:
Application Recommended Dilution ELISA 1:1000-1:2000 WB 1:200-1:1000 IHC 1:50-1:200 -
Protocols:
-
儲存條件:Upon receipt, store at -20°C or -80°C. Avoid repeated freeze.
-
貨期:Basically, we can dispatch the products out in 1-3 working days after receiving your orders. Delivery time maybe differs from different purchasing way or location, please kindly consult your local distributors for specific delivery time.
-
用途:For Research Use Only. Not for use in diagnostic or therapeutic procedures.
相關產品
靶點詳情
-
功能:Microtubule-associated protein that exhibits cell cycle-dependent localization and can inhibit cell proliferation and migration.
-
基因功能參考文獻:
- MARVELD1 substantially inhibits nonsense-mediated RNA decay by decreasing the pioneer round of translation but not steady-state translation, and is an important component of the molecular machinery containing UPF1 and Y14. MARVELD1 promotes the dissociation of SMG1 from UPF1, resulting in the repression of serine phosphorylation of UPF1, and subsequently blocks the recruitment of SMG5. PMID: 23826386
- Study demonstrates that MARVELD1-mediated balance of integrin beta1 and beta4 regulates cell surface ultrastructure and epithelial-mesenchymal transition phenotype of non-small cell lung cancer (NSCLC). PMID: 26509557
- MARVELD1 silencing is an appealing diagnostic biomarker for lung cancer. PMID: 25520033
- Importin-beta1 mediates the non-classical nucleocytoplasmic transport of MARVELD1. PMID: 26107903
- MARVELD1 plays a role in pre-mRNA processing of integrin beta1. PMID: 24055813
- Our findings suggest that MARVELD1 is a tumor suppressor by negatively regulating proliferation, tumor growth and chemosensitivity of HCC cells via increasing p53 and p16 in vitro and in vivo. PMID: 22320884
- MARVELD1 protein is located in nucleus instead of cell membrane in several different tumors, in males and in females. PMID: 19364627
顯示更多
收起更多
-
亞細胞定位:Cell membrane; Multi-pass membrane protein. Cytoplasm, cytoskeleton. Nucleus.
-
組織特異性:Widely expressed in normal tissues. Down-regulated in multiple primary tumors.
-
數據庫鏈接:
Most popular with customers
-
-
YWHAB Recombinant Monoclonal Antibody
Applications: ELISA, WB, IHC, IF, FC
Species Reactivity: Human, Mouse, Rat
-
Phospho-YAP1 (S127) Recombinant Monoclonal Antibody
Applications: ELISA, WB, IHC
Species Reactivity: Human
-
-
-
-
-